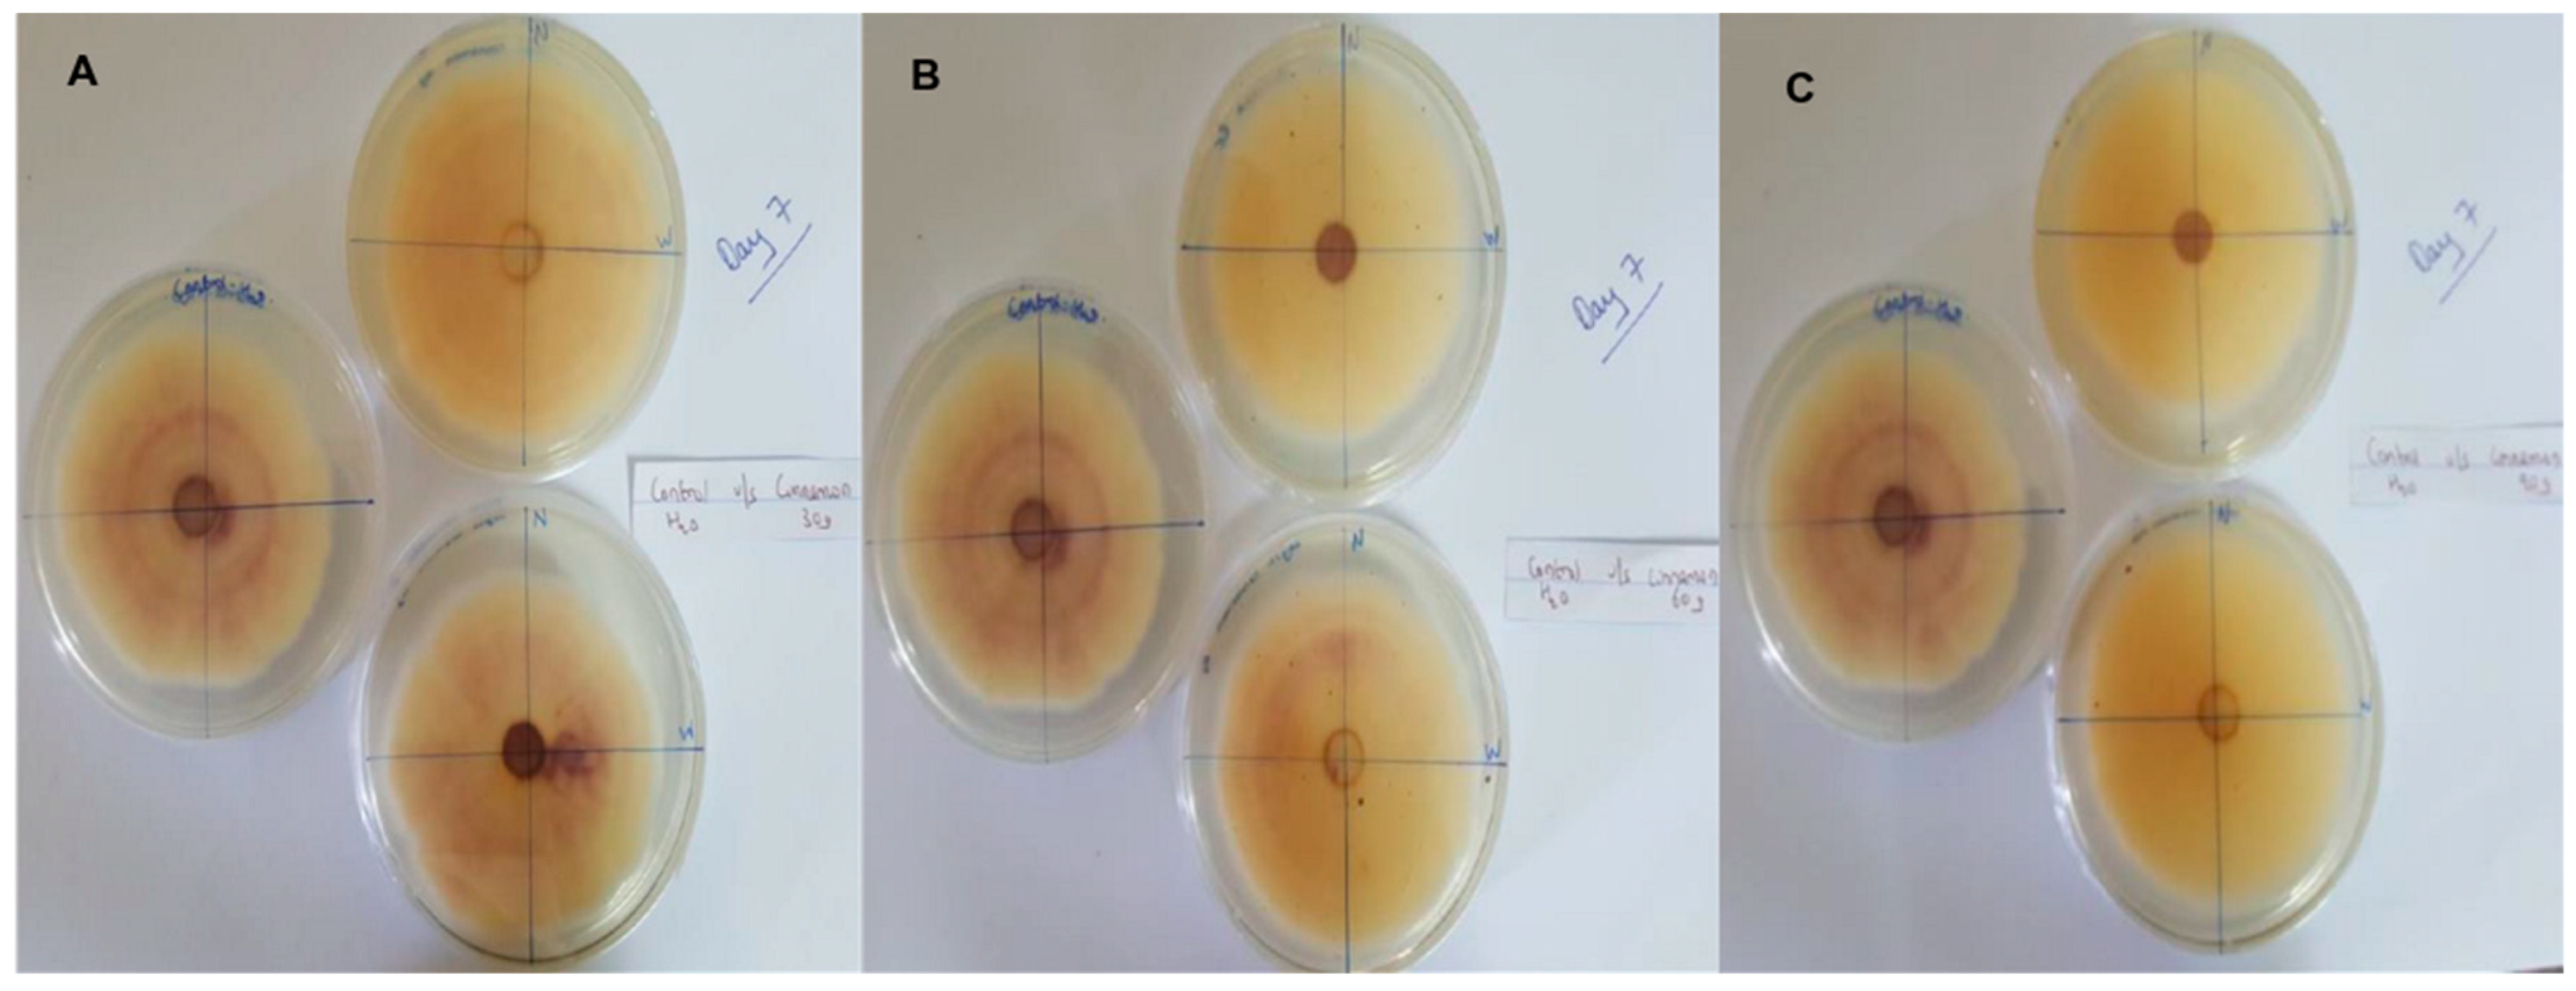
Pathogens 13 00436 g005
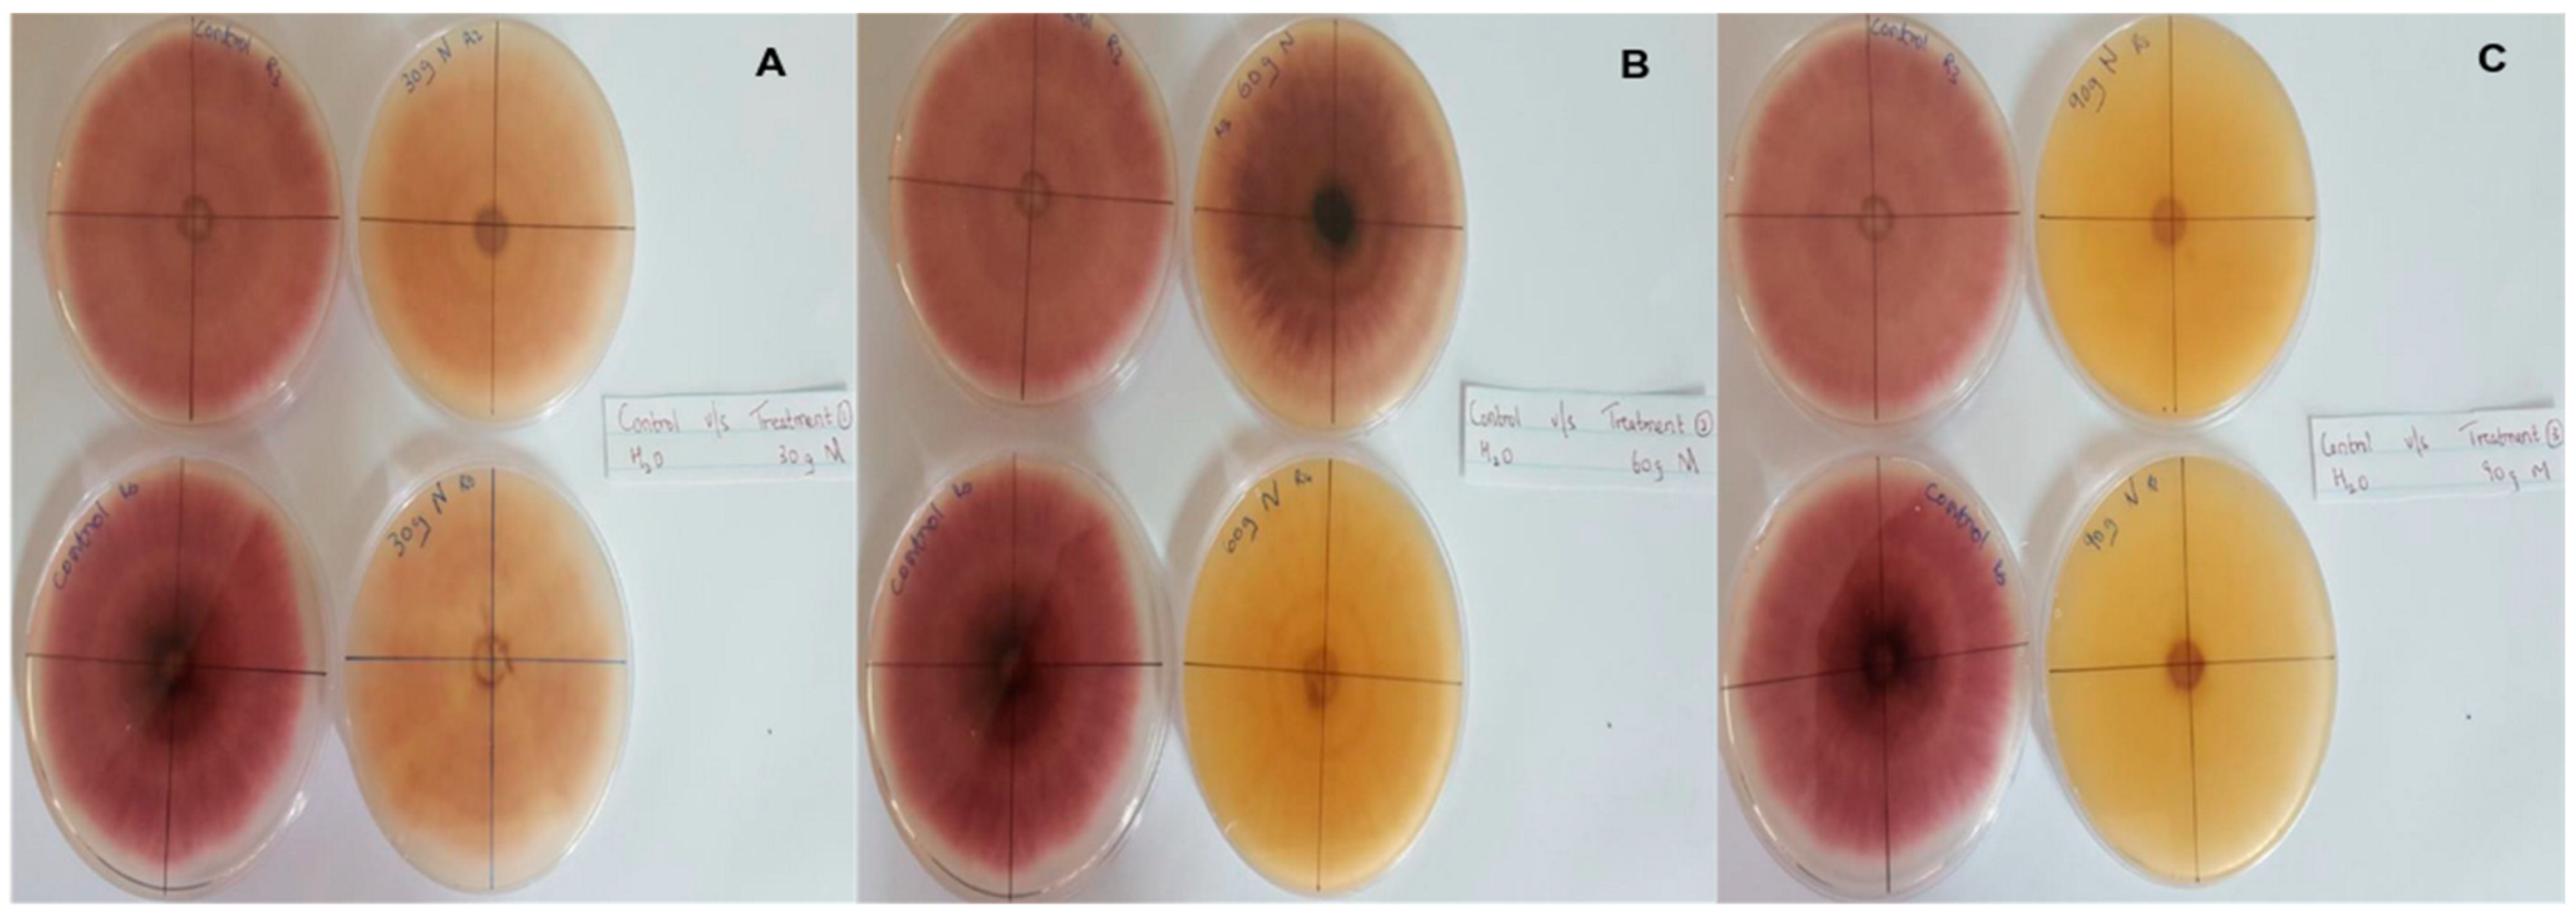
Pathogens 13 00436 g007

Antioxidant and Antifungal Properties of Cinnamon, Cloves, Melia azedarach L. and Ocimum gratissimum L. Extracts against Fusarium oxysporum Isolated from Infected Vegetables in Mauritius
Abstract
1. Introduction
2. Materials and Methods
2.1. Survey on Damages Caused by Fusarium
2.2. Sample Collection
2.3. Isolation of Fungi from Infected Samples
2.4. Single Spore Isolation
2.5. DNA Extraction
2.6. PCR, Sequencing and Analysis
2.7. Preparation of Crude Extracts
2.8. Phytochemical Analysis
2.9. Antioxidant Capacity Assays
2.9.1. Ferric Reducing Antioxidant Power (FRAP) Assay
2.9.2. DPPH Radical Scavenging Activity
2.9.3. Antifungal Assay
3. Results
3.1. Prevalence of Disease
3.2. Isolation and Morphological Characteristics of Fungi
3.3. Phylogenetic Analysis of the Isolates
3.4. Preparation of Plant Extracts
3.5. Phytochemical Analysis
3.6. Antioxidant Activity of Extracts
3.7. Antifungal Assay
4. Discussion
4.1. Phylogenetic Analysis of Fusarium Isolates
4.2. Extent of Fusarium Infection in Vegetable Fields
4.3. Biological Activities of Plant Extracts
5. Conclusions
Supplementary Materials
Author Contributions
Funding
Institutional Review Board Statement
Informed Consent Statement
Data Availability Statement
Conflicts of Interest
References
- Bahram, M.; Netherway, T. Fungi as Mediators Linking Organisms and Ecosystems. FEMS Microbiol. Rev. 2022, 46, fuab058. [Google Scholar] [CrossRef] [PubMed]
- Hawksworth, D.L.; Lücking, R. Fungal Diversity Revisited: 2.2 to 3.8 Million Species. Microbiol. Spectr. 2017, 5, 10–1128. [Google Scholar] [CrossRef] [PubMed]
- Fang, W.; Devkota, S.; Arunachalam, K.; Phyo, K.M.M.; Shakya, B. Systematic Review of Fungi, Their Diversity and Role in Ecosystem Services from the Far Eastern Himalayan Landscape (FHL). Heliyon 2023, 9, e12756. [Google Scholar] [CrossRef] [PubMed]
- Cunliffe, M. Who Are the Marine Fungi? Environ. Microbiol. 2023, 25, 131–134. [Google Scholar] [CrossRef] [PubMed]
- Naranjo-Ortiz, M.A.; Gabaldón, T. Fungal Evolution: Major Ecological Adaptations and Evolutionary Transitions. Biol. Rev. 2019, 94, 1443–1476. [Google Scholar] [CrossRef] [PubMed]
- Peng, Y.; Li, S.J.; Yan, J.; Tang, Y.; Cheng, J.P.; Gao, A.J.; Yao, X.; Ruan, J.J.; Xu, B.L. Research Progress on Phytopathogenic Fungi and Their Role as Biocontrol Agents. Front. Microbiol. 2021, 12, 670135. [Google Scholar] [CrossRef]
- Sun, S.; Hoy, M.J.; Heitman, J. Fungal Pathogens. Curr. Biol. 2020, 30, R1163–R1169. [Google Scholar] [CrossRef] [PubMed]
- Goss, E.M.; Tabima, J.F.; Cooke, D.E.L.; Restrepo, S.; Fry, W.E.; Forbes, G.A.; Fieland, V.J.; Cardenas, M.; Grünwald, N.J. The Irish Potato Famine Pathogen Phytophthora Infestans Originated in Central Mexico Rather than the Andes. Proc. Natl. Acad. Sci. USA 2014, 111, 8791–8796. [Google Scholar] [CrossRef] [PubMed]
- Mwangi, R.W.; Mustafa, M.; Charles, K.; Wagara, I.W.; Kappel, N. Selected Emerging and Reemerging Plant Pathogens Affecting the Food Basket: A Threat to Food Security. J. Agric. Food Res. 2023, 14, 100827. [Google Scholar] [CrossRef]
- Beccari, G.; Hao, G.; Liu, H. Editorial: Fusarium Pathogenesis: Infection Mechanisms and Disease Progression in Host Plants. Front. Plant Sci. 2022, 13, 1020404. [Google Scholar] [CrossRef]
- Ajmal, M.; Hussain, A.; Ali, A.; Chen, H.; Lin, H. Strategies for Controlling the Sporulation in Fusarium spp. J. Fungi 2022, 9, 10. [Google Scholar] [CrossRef]
- Ekwomadu, T.I.; Mwanza, M. Fusarium Fungi Pathogens, Identification, Adverse Effects, Disease Management, and Global Food Security: A Review of the Latest Research. Agriculture 2023, 13, 1810. [Google Scholar] [CrossRef]
- Perincherry, L.; Lalak-Kańczugowska, J.; Stępień, Ł. Fusarium-Produced Mycotoxins in Plant-Pathogen Interactions. Toxins 2019, 11, 664. [Google Scholar] [CrossRef] [PubMed]
- Chen, A.; Islam, T.; Ma, Z. An Integrated Pest Management Program for Managing Fusarium Head Blight Disease in Cereals. J. Integr. Agric. 2022, 21, 3434–3444. [Google Scholar] [CrossRef]
- Sampaio, A.M.; de Araújo, S.S.; Rubiales, D.; Vaz Patto, M.C. Fusarium Wilt Management in Legume Crops. Agronomy 2020, 10, 1073. [Google Scholar] [CrossRef]
- Feng, H.; Gonzalez Viejo, C.; Vaghefi, N.; Taylor, P.W.J.; Tongson, E.; Fuentes, S. Early Detection of Fusarium Oxysporum Infection in Processing Tomatoes (Solanum Lycopersicum) and Pathogen–Soil Interactions Using a Low-Cost Portable Electronic Nose and Machine Learning Modeling. Sensors 2022, 22, 8645. [Google Scholar] [CrossRef] [PubMed]
- Panno, S.; Davino, S.; Caruso, A.G.; Bertacca, S.; Crnogorac, A.; Mandić, A.; Noris, E.; Matić, S. A Review of the Most Common and Economically Important Diseases That Undermine the Cultivation of Tomato Crop in the Mediterranean Basin. Agronomy 2021, 11, 2188. [Google Scholar] [CrossRef]
- Dulymamode, R.; Cannon, P.F.; Peerally, A. Fungi on Endemic Plants of Mauritius. Mycol. Res. 2001, 105, 1472–1479. [Google Scholar] [CrossRef]
- Mamode Ally, N.; Neetoo, H.; Ranghoo-Sanmukhiya, V.M.; Ameerkhan, A.B.; Vojvodić, M.; Bulajić, A. First Report of Fusarium Acacia-mearnsii Causing Leaf Blight on Pumpkin in Mauritius. New Dis. Rep. 2023, 48, 12207. [Google Scholar] [CrossRef]
- Safari, Z.S.; Ding, P.; Nakasha, J.J.; Yusoff, S.F. Controlling Fusarium Oxysporum Tomato Fruit Rot under Tropical Condition Using Both Chitosan and Vanillin. Coatings 2021, 11, 367. [Google Scholar] [CrossRef]
- El-Aswad, A.F.; Aly, M.I.; Alsahaty, S.A.; Basyony, A.B.A. Efficacy Evaluation of Some Fumigants against Fusarium Oxysporum and Enhancement of Tomato Growth as Elicitor-Induced Defense Responses. Sci. Rep. 2023, 13, 2479. [Google Scholar] [CrossRef] [PubMed]
- El-Baky, N.A.; Amara, A.A.A.F. Recent Approaches towards Control of Fungal Diseases in Plants: An Updated Review. J. Fungi 2021, 7, 900. [Google Scholar] [CrossRef] [PubMed]
- Ali, W.M.; Abdel-Mageed, M.A.; Hegazy, M.G.A.; Abou-Shlell, M.K.; Sultan, S.M.E.; Salama, E.A.A.; Yousef, A.F. Biocontrol Agent of Root-Knot Nematode Meloidogyne Javanica and Root-Rot Fungi, Fusarium Solani in Okra Morphological, Anatomical Characteristics and Productivity under Greenhouse Conditions. Sci. Rep. 2023, 13, 11103. [Google Scholar] [CrossRef] [PubMed]
- Umesha, S.; Manukumar, H.M.; Raghava, S. A Rapid Method for Isolation of Genomic DNA from Food-Borne Fungal Pathogens. 3 Biotech 2016, 6, 123. [Google Scholar] [CrossRef] [PubMed]
- Thompson, J.D.; Higgins, D.G.; Gibson, T.J. CLUSTAL W: Improving the Sensitivity of Progressive Multiple Sequence Alignment through Sequence Weighting, Position-Specific Gap Penalties and Weight Matrix Choice. Nucleic Acids Res. 1994, 22, 4673–4680. [Google Scholar] [CrossRef]
- Swofford, D.L. PAUP*. Phylogenetic Analysis Using Parsimony (*and Other Methods). 1998. Available online: https://www.ucl.ac.uk/cecd/downloads/PAUP%20command%20reference%20manual.pdf (accessed on 20 February 2024).
- Saitou, N.; Nei, M. The Neighbor-Joining Method: A New Method for Reconstructing Phylogenetic Trees. Mol. Biol. Evol. 1987, 4, 406–425. [Google Scholar] [CrossRef]
- Felsenstein, J. Evolutionary Trees from DNA Sequences: A Maximum Likelihood Approach. J. Mol. Evol. 1981, 17, 368–376. [Google Scholar] [CrossRef]
- Kimura, M. A Simple Method for Estimating Evolutionary Rates of Base Substitutions through Comparative Studies of Nucleotide Sequences. J. Mol. Evol. 1980, 16, 111–120. [Google Scholar] [CrossRef]
- Guindon, S.; Gascuel, O. A Simple, Fast, and Accurate Algorithm to Estimate Large Phylogenies by Maximum Likelihood. Syst. Biol. 2003, 52, 696–704. [Google Scholar] [CrossRef]
- Darriba, D.; Taboada, G.L.; Doallo, R.; Posada, D. JModelTest 2: More Models, New Heuristics and Parallel Computing. Nat. Methods 2012, 9, 772. [Google Scholar] [CrossRef]
- Ayalew Tiruneh, T.; Ayalew, G.; Chekol Abebe, E.; Mengie Ayele, T. Phytochemical Investigation and Determination of Antibacterial Activity of Solvent Leave Extracts of Carissa Spinarum. Infect. Drug Resist. 2022, 15, 807–819. [Google Scholar] [CrossRef]
- Alemu, M.; Lulekal, E.; Asfaw, Z.; Warkineh, B.; Debella, A.; Abebe, A.; Degu, S.; Debebe, E. Antibacterial Activity and Phytochemical Screening of Traditional Medicinal Plants Most Preferred for Treating Infectious Diseases in Habru District, North Wollo Zone, Amhara Region, Ethiopia. PLoS ONE 2024, 19, e0300060. [Google Scholar] [CrossRef] [PubMed]
- Godlewska, K.; Pacyga, P.; Najda, A.; Michalak, I. Investigation of Chemical Constituents and Antioxidant Activity of Biologically Active Plant-Derived Natural Products. Molecules 2023, 28, 5572. [Google Scholar] [CrossRef] [PubMed]
- Usman, H.; Abdulrahman, F.I.; Usman, A. Qualitative Phytochemical Screening and in Vitro Antimicrobial Effects of Methanol Stem Bark Extract of Ficus Thonningii (Moraceae). Afr. J. Tradit. Complement. Altern. Med. 2010, 6. [Google Scholar] [CrossRef] [PubMed]
- Shirazi, O.U.; Khattak, M.M.A.K.; Shukri, N.A.M.; Nasyrik, N.M.A. Determination of Total Phenolic, Flavonoid Content and Free Radical Scavenging Activities of Common Herbs and Spices. J. Pharmacogn. Phytochem. 2014, 3, 104–108. [Google Scholar]
- Niño-Sánchez, J.; Casado-Del Castillo, V.; Tello, V.; De Vega-Bartol, J.J.; Ramos, B.; Sukno, S.A.; Díaz Mínguez, J.M. The FTF Gene Family Regulates Virulence and Expression of SIX Effectors in Fusarium Oxysporum. Mol. Plant Pathol. 2016, 17, 1124–1139. [Google Scholar] [CrossRef] [PubMed]
- Nelson, P.E. Life Cycle and Epidemiology of Fusarium Oxysporum. In Fungal Wilt Diseases of Plants; Beckmann, C.H., Ed.; APS Press: St. Paul, MI, USA, 1981; pp. 51–79. [Google Scholar]
- Booth, C. The Genus Fusarium; Commonwealth Mycological Institute: London, UK, 1971. [Google Scholar]
- Nelson, P.E.; Toussoun, T.A.; Marasas, W.F.O. Fusarium Species: An Illustrated Manual for Identification; Pennsylvania State University Press: University Park, PA, USA, 1983. [Google Scholar]
- Tiwari, R.K.; Kumar, R.; Sharma, S.; Sagar, V.; Aggarwal, R.; Naga, K.C.; Lal, M.K.; Chourasia, K.N.; Kumar, D.; Kumar, M. Potato Dry Rot Disease: Current Status, Pathogenomics and Management. 3 Biotech 2020, 10, 503. [Google Scholar] [CrossRef] [PubMed]
- Soleha, S.; Muslim, A.; Suwandi, S.; Kadir, S.; Pratama, R. The Identification and Pathogenicity of Fusarium Oxysporum Causing Acacia Seedling Wilt Disease. J. Res. 2022, 33, 711–719. [Google Scholar] [CrossRef]
- Edel-Hermann, V.; Lecomte, C. Current Status of Fusarium Oxysporum Formae Speciales and Races. Phytopathology 2019, 109, 512–530. [Google Scholar] [CrossRef]
- Jangir, P.; Mehra, N.; Sharma, K.; Singh, N.; Rani, M.; Kapoor, R. Secreted in Xylem Genes: Drivers of Host Adaptation in Fusarium Oxysporum. Front. Plant Sci. 2021, 12, 628611. [Google Scholar] [CrossRef]
- Singha, I.M.; Kakoty, Y.; Unni, B.G.; Das, J.; Kalita, M.C. Identification and Characterization of Fusarium Sp. Using ITS and RAPD Causing Fusarium Wilt of Tomato Isolated from Assam, North East India. J. Genet. Eng. Biotechnol. 2016, 14, 99–105. [Google Scholar] [CrossRef]
- Zarrin, M.; Ganj, F.; Faramarzi, S. Analysis of the RDNA Internal Transcribed Spacer Region of the Fusarium Species by Polymerase Chain Reaction-Restriction Fragment Length Polymorphism. Biomed. Rep. 2016, 4, 471–474. [Google Scholar] [CrossRef]
- O’Donnell, K.; Ward, T.J.; Robert, V.A.R.G.; Crous, P.W.; Geiser, D.M.; Kang, S. DNA Sequence-Based Identification of Fusarium: Current Status and Future Directions. Phytoparasitica 2015, 43, 583–595. [Google Scholar] [CrossRef]
- van Dam, P.; Rep, M. The Distribution of Miniature Impala Elements and SIX Genes in the Fusarium Genus Is Suggestive of Horizontal Gene Transfer. J. Mol. Evol. 2017, 85, 14–25. [Google Scholar] [CrossRef]
- Vlaardingerbroek, I.; Beerens, B.; Rose, L.; Fokkens, L.; Cornelissen, B.J.C.; Rep, M. Exchange of Core Chromosomes and Horizontal Transfer of Lineage-specific Chromosomes in Fusarium Oxysporum. Environ. Microbiol. 2016, 18, 3702–3713. [Google Scholar] [CrossRef]
- Ma, L.-J.; van der Does, H.C.; Borkovich, K.A.; Coleman, J.J.; Daboussi, M.-J.; Di Pietro, A.; Dufresne, M.; Freitag, M.; Grabherr, M.; Henrissat, B.; et al. Comparative Genomics Reveals Mobile Pathogenicity Chromosomes in Fusarium. Nature 2010, 464, 367–373. [Google Scholar] [CrossRef]
- Mauritius Meteorological Services. Climate of Mauritius. 2024. Available online: http://metservice.intnet.mu/climate-services/climate-of-mauritius.php#:~:text=Mean%20summer%20temperature%20is%2024.7,is%20only%204.3%20degrees%20Celsius (accessed on 13 December 2023).
- Richter, M. Climate aspects of the tropics. In Tropical Forestry Handbook; Pancel, L., Köhl, M., Eds.; Springer: Berlin/Heidelberg, Germany, 2016; pp. 285–291. [Google Scholar]
- Balek, J. Climatology of The Tropics. In Hydrology and Water Resources in Tropical Regions; Balek, J., Ed.; Elsevier Science Publishers: Amsterdam, The Netherlands, 1983; Volume 18, pp. 22–69. [Google Scholar]
- Fernández-Ledesma, C.M.; Garcés-Fiallos, F.R.; Rosso, F.; Cordero, N.; Ferraz, S.; Durigon, A.; Portalanza, D. Assessing the Risk of Fusarium Oxysporum f. Sp. Cubense Tropical Race 4 Outbreaks in Ecuadorian Banana Crops Using Spatial Climatic Data. Sci. Agropecu. 2023, 14, 301–312. [Google Scholar] [CrossRef]
- Duvnjak, T.; Vrandecic, K.; Sudaric, A.; Cosic, J.; Siber, T.; Matosa Kocar, M. First Report of Hemp Fusarium Wilt Caused by Fusarium Oxysporum in Croatia. Plants 2023, 12, 3305. [Google Scholar] [CrossRef]
- Timmusk, S.; Nevo, E.; Ayele, F.; Noe, S.; Niinemets, Ü. Fighting Fusarium Pathogens in the Era of Climate Change: A Conceptual Approach. Pathogens 2020, 9, 419. [Google Scholar] [CrossRef]
- Velásquez, A.C.; Castroverde, C.D.M.; He, S.Y. Plant–Pathogen Warfare under Changing Climate Conditions. Curr. Biol. 2018, 28, R619–R634. [Google Scholar] [CrossRef]
- Rodrigues de Queiroz, A.; Hines, C.; Brown, J.; Sahay, S.; Vijayan, J.; Stone, J.M.; Bickford, N.; Wuellner, M.; Glowacka, K.; Buan, N.R.; et al. The Effects of Exogenously Applied Antioxidants on Plant Growth and Resilience. Phytochem. Rev. 2023, 22, 407–447. [Google Scholar] [CrossRef]
- Desoky, E.-S.M.; Selem, E.; Abo El-Maati, M.F.; Hassn, A.A.S.A.; Belal, H.E.E.; Rady, M.M.; AL-Harbi, M.S.; Ali, E.F. Foliar Supplementation of Clove Fruit Extract and Salicylic Acid Maintains the Performance and Antioxidant Defense System of Solanum Tuberosum, L. under Deficient Irrigation Regimes. Horticulturae 2021, 7, 435. [Google Scholar] [CrossRef]
- Selem, E.; Hassan, A.A.S.A.; Awad, M.F.; Mansour, E.; Desoky, E.-S.M. Impact of Exogenously Sprayed Antioxidants on Physio-Biochemical, Agronomic, and Quality Parameters of Potato in Salt-Affected Soil. Plants 2022, 11, 210. [Google Scholar] [CrossRef]
- Chojak-Koźniewska, J.; Kuźniak, E.; Zimny, J. The Effects of Combined Abiotic and Pathogen Stress in Plants: Insights from Salinity and Pseudomonas Syringae Pv Lachrymans Interaction in Cucumber. Front. Plant Sci. 2018, 9, 01691. [Google Scholar] [CrossRef] [PubMed]
- Tiwari, R.K.; Lal, M.K.; Kumar, R.; Mangal, V.; Kumar, A.; Kumar, R.; Sharma, S.; Sagar, V.; Singh, B. Salt Stress Influences the Proliferation of Fusarium Solani and Enhances the Severity of Wilt Disease in Potato. Heliyon 2024, 10, e26718. [Google Scholar] [CrossRef] [PubMed]
- Mostafa, A.A.-F.; Yassin, M.T.; Al–Askar, A.A.; Al-Otibi, F.O. Phytochemical Analysis, Antiproliferative and Antifungal Activities of Different Syzygium Aromaticum Solvent Extracts. J. King Saud. Univ. Sci. 2023, 35, 102362. [Google Scholar] [CrossRef]
- Biernasiuk, A.; Baj, T.; Malm, A. Clove Essential Oil and Its Main Constituent, Eugenol, as Potential Natural Antifungals against Candida Spp. Alone or in Combination with Other Antimycotics Due to Synergistic Interactions. Molecules 2022, 28, 215. [Google Scholar] [CrossRef]
- Abdul Aziz, A.H.; Rizkiyah, D.N.; Qomariyah, L.; Irianto, I.; Che Yunus, M.A.; Putra, N.R. Unlocking the Full Potential of Clove (Syzygium Aromaticum) Spice: An Overview of Extraction Techniques, Bioactivity, and Future Opportunities in the Food and Beverage Industry. Processes 2023, 11, 2453. [Google Scholar] [CrossRef]
- Gengatharan, A.; Rahim, M.H.A. The Application of Clove Extracts as a Potential Functional Component in Active Food Packaging Materials and Model Food Systems: A Mini-Review. Appl. Food Res. 2023, 3, 100283. [Google Scholar] [CrossRef]
- Li, C.; Xu, H.; Chen, X.; Chen, J.; Li, X.; Qiao, G.; Tian, Y.; Yuan, R.; Su, S.; Liu, X.; et al. Aqueous Extract of Clove Inhibits Tumor Growth by Inducing Autophagy through AMPK/ULK Pathway. Phytother. Res. 2019, 33, 1794–1804. [Google Scholar] [CrossRef]
- Hassan, S.M.; El-Bebany, A.F.; Salem, M.Z.M.; Komeil, D.A. Productivity and Post-Harvest Fungal Resistance of Hot Pepper as Affected by Potassium Silicate, Clove Extract Foliar Spray and Nitrogen Application. Plants 2021, 10, 662. [Google Scholar] [CrossRef]
- Lee, H.-S.; Kim, Y. Myricetin Disturbs the Cell Wall Integrity and Increases the Membrane Permeability of Candida Albicans. J. Microbiol. Biotechnol. 2022, 32, 37–45. [Google Scholar] [CrossRef] [PubMed]
- Li, Z.-J.; Abula, A.; Abulizi, A.; Wang, C.; Dou, Q.; Maimaiti, Y.; Abudouaini, A.; Huo, S.-X.; Aibai, S. Ellagic Acid Inhibits Trichophyton Rubrum Growth via Affecting Ergosterol Biosynthesis and Apoptotic Induction. Evid. Based Complement. Altern. Med. 2020, 2020, 1–8. [Google Scholar] [CrossRef] [PubMed]
- Rhimi, W.; Aneke, C.I.; Annoscia, G.; Otranto, D.; Boekhout, T.; Cafarchia, C. Effect of Chlorogenic and Gallic Acids Combined with Azoles on Antifungal Susceptibility and Virulence of Multidrug-Resistant Candida Spp. and Malassezia Furfur Isolates. Med. Mycol. 2020, 58, 1091–1101. [Google Scholar] [CrossRef] [PubMed]
- Godlewska, K.; Ronga, D.; Michalak, I. Plant Extracts - Importance in Sustainable Agriculture. Ital. J. Agron. 2021, 16, 1851. [Google Scholar] [CrossRef]
- Senhaji, O.; Faid, M.; Elyachioui, M.; Dehhaoui, M. Antifungal Activity of Different Cinnamon Extracts. J. Mycol. Med. 2005, 15, 220–229. [Google Scholar] [CrossRef]
- Mvuemba, H.N.; Green, S.E.; Tsopmo, A.; Avis, T.J. Antimicrobial Efficacy of Cinnamon, Ginger, Horseradish and Nutmeg Extracts against Spoilage Pathogens. Phytoprotection 2010, 90, 65–70. [Google Scholar] [CrossRef]
- Olamilosoye, K.P.; Akomolafe, R.O.; Akinsomisoye, O.S.; Adefisayo, M.A.; Alabi, Q.K. The Aqueous Extract of Ocimum Gratissimum Leaves Ameliorates Acetic Acid-Induced Colitis via Improving Antioxidant Status and Hematological Parameters in Male Wistar Rats. Egypt. J. Basic Appl. Sci. 2018, 5, 220–227. [Google Scholar] [CrossRef]
- Mohr, F.B.M.; Lermen, C.; Gazim, Z.C.; Gonçalves, J.E.; Alberton, O. Antifungal Activity, Yield, and Composition of Ocimum Gratissimum Essential Oil. Genet. Mol. Res. 2017, 16, 1–10. [Google Scholar] [CrossRef]

| Plant Chemical Constituent | Methanol-Based Extraction | Water-Based Extraction | ||||||
|---|---|---|---|---|---|---|---|---|
| Melia azedarach L. | Ocimum gratissimum L. | Cinnamon | Cloves | Melia azedarach L. | Ocimum gratissimum L. | Cinnamon | Cloves | |
| Flavonoids | − | − | + | + | − | − | + | + |
| Saponins | − | − | + | + | − | − | + | + |
| Tanins | + | + | + | + | + | + | + | + |
| Phenols | + | − | + | + | − | − | + | + |
| Proteins | + | + | + | + | + | + | + | + |
| Alkaloids | + | + | + | + | − | − | + | + |
| Cardiac Glycosides | + | + | + | + | − | + | + | − |
| Terpenoids | + | + | + | + | + | + | + | + |
| Carbohydrates | + | + | + | + | + | + | + | + |
| Ferric Reducing Antioxidant Power Assay (FRAP) | DPPH Radical Scavenging Activity | ||
|---|---|---|---|
| Methanol-based extraction | Melia azedarach L. | 0.119 | 0.338 |
| Ocimum gratissimum L. | 0.159 | 0.209 | |
| Cinnamon | 0.260 | 0.050 | |
| Cloves | −0.103 | 0.081 | |
| Water-based extraction | Melia azedarach L. | 0.434 | 0.601 |
| Ocimum gratissimum L. | 0.292 | 0.697 | |
| Cinnamon | 0.107 | 0.396 | |
| Cloves | 0.333 | 0.008 |
| Plant Extract | Amount Used (g) Per L | Incubation Period (h) | ||||||
|---|---|---|---|---|---|---|---|---|
| 24 | 48 | 72 | 96 | 120 | 144 | 168 | ||
| Melia azedarach L. | 30 | 16.4 ± 4.8 | 4.9 ± 0.4 a | 6.9 ± 6.5 a | 5.3 ± 5.0 a | 3.6 ± 3.0 a | 2.1 ± 0.8 a | 1.4 ± 0.02 a |
| 60 | 16.4 ± 4.7 | 4.9 ± 0.4 a | 6.9 ± 6.5 a | 5.3 ± 5.0 a | 3.6 ± 3.0 a | 2.2 ± 0.8 a | 1.4 ± 0.01 a | |
| 90 | 16.4 ± 4.7 | 4.9 ± 0.4 a | 4.9 ± 3.1 a | 2.4 ± 0.1 a | 1.8 ± 0.1 a | 1.6 ± 0.03 a | 1.4 ± 0.02 a | |
| Ocimum gratissimum L. | 30 | 29.9 ± 8.7 | 19.4 ± 6.9 | 18.9 ± 8.5 | 15.3 ± 7.9 | 13.4 ± 4.3 | 10.8 ± 3.9 | 7.1 ± 1.4 a |
| 60 | 39.2 ± 14.9 | 27.7 ± 3.6 | 28.3 ± 0.9 | 21.0 ± 3.1 | 19.0 ± 3.6 | 21.8 ± 1.8 | 12.4 ± 0.9 | |
| 90 | 55.9 ± 10.1 | 30.7 ± 8.8 | 37.3 ± 2.4 | 27.3 ± 2.0 | 21.5 ± 0.7 | 23.3 ± 1.8 | 15.3 ± 1.9 | |
| Cloves | 30 | 100.0 ± 0.00 | 91.7 ± 3.3 | 87.9 ± 0.8 | 87.4 ± 2.1 | 83.4 ± 0.5 | 81.4 ± 0.4 | 78.6 ± 0.3 |
| 60 | 100.0 ± 0.0 | 100.0 ± 0.0 | 100.0 ± 0.0 | 100.0 ± 0.0 | 100.0 ± 0.0 | 100.0 ± 0.0 | 100.0 ± 0.0 | |
| 90 | 100.0 ± 0.0 | 100.0 ± 0.0 | 100.0 ± 0.0 | 100.0 ± 0.0 | 100.0 ± 0.0 | 100.0 ± 0.0 | 100.0 ± 0.0 | |
| Cinnamon | 30 | 56.7 ± 3.0 | 32.8 ± 1.9 | 27.2 ± 1.4 | 28.0 ± 2.7 | 18.3 ± 3.4 | 18.7 ± 0.4 | 8.7 ± 6.5 |
| 60 | 56.7 ± 2.9 | 31.2 ± 5.9 | 23.2 ± 2.3 | 26.6 ± 2.9 | 18.4 ± 3.3 | 13.9 ± 3.8 | 10.4 ± 2.9 | |
| 90 | 59.7 ± 4.0 | 31.4 ± 8.7 | 28.2 ± 2.3 | 31.9 ± 3.9 | 14.9 ± 11.4 | 13.6 ± 10.7 | 8.6 ± 6.6 | |
| Mancozeb (control) | 4 | 16.1 ± 9.7 | 14.5 ± 8.0 | 12.8 ± 8.3 | 12.4 ± 4.3 | 10.3 ± 5.9 a | 9.2 ± 5.4 a | 4.7 ± 2.9 a |
| 8 | 20.1 ± 2.0 | 8.0 ± 4.9 a | 10.8 ± 8.5 a | 9.1 ± 7.9 a | 9.7 ± 7.3 a | 12.3 ± 6.4 | 8.6 ± 5.1 | |
| 12 | 60.4 ± 6.1 | 14.3 ± 8.7 | 19.4 ± 5.8 | 16.8 ± 8.4 | 16.57 ± 0.4 | 15.5 ± 4.0 | 10.5 ± 2.9 | |
Disclaimer/Publisher’s Note: The statements, opinions and data contained in all publications are solely those of the individual author(s) and contributor(s) and not of MDPI and/or the editor(s). MDPI and/or the editor(s) disclaim responsibility for any injury to people or property resulting from any ideas, methods, instructions or products referred to in the content. |
© 2024 by the authors. Licensee MDPI, Basel, Switzerland. This article is an open access article distributed under the terms and conditions of the Creative Commons Attribution (CC BY) license (https://creativecommons.org/licenses/by/4.0/).
Share and Cite
Jeewon, R.; Pudaruth, S.B.; Bhoyroo, V.; Aullybux, A.A.; Rajeshkumar, K.C.; Alrefaei, A.F. Antioxidant and Antifungal Properties of Cinnamon, Cloves, Melia azedarach L. and Ocimum gratissimum L. Extracts against Fusarium oxysporum Isolated from Infected Vegetables in Mauritius. Pathogens 2024, 13, 436. https://doi.org/10.3390/pathogens13060436
Jeewon R, Pudaruth SB, Bhoyroo V, Aullybux AA, Rajeshkumar KC, Alrefaei AF. Antioxidant and Antifungal Properties of Cinnamon, Cloves, Melia azedarach L. and Ocimum gratissimum L. Extracts against Fusarium oxysporum Isolated from Infected Vegetables in Mauritius. Pathogens. 2024; 13(6):436. https://doi.org/10.3390/pathogens13060436
Chicago/Turabian StyleJeewon, Rajesh, Shaan B. Pudaruth, Vishwakalyan Bhoyroo, Aadil Ahmad Aullybux, Kunhiraman C. Rajeshkumar, and Abdulwahed Fahad Alrefaei. 2024. "Antioxidant and Antifungal Properties of Cinnamon, Cloves, Melia azedarach L. and Ocimum gratissimum L. Extracts against Fusarium oxysporum Isolated from Infected Vegetables in Mauritius" Pathogens 13, no. 6: 436. https://doi.org/10.3390/pathogens13060436
APA StyleJeewon, R., Pudaruth, S. B., Bhoyroo, V., Aullybux, A. A., Rajeshkumar, K. C., & Alrefaei, A. F. (2024). Antioxidant and Antifungal Properties of Cinnamon, Cloves, Melia azedarach L. and Ocimum gratissimum L. Extracts against Fusarium oxysporum Isolated from Infected Vegetables in Mauritius. Pathogens, 13(6), 436. https://doi.org/10.3390/pathogens13060436







